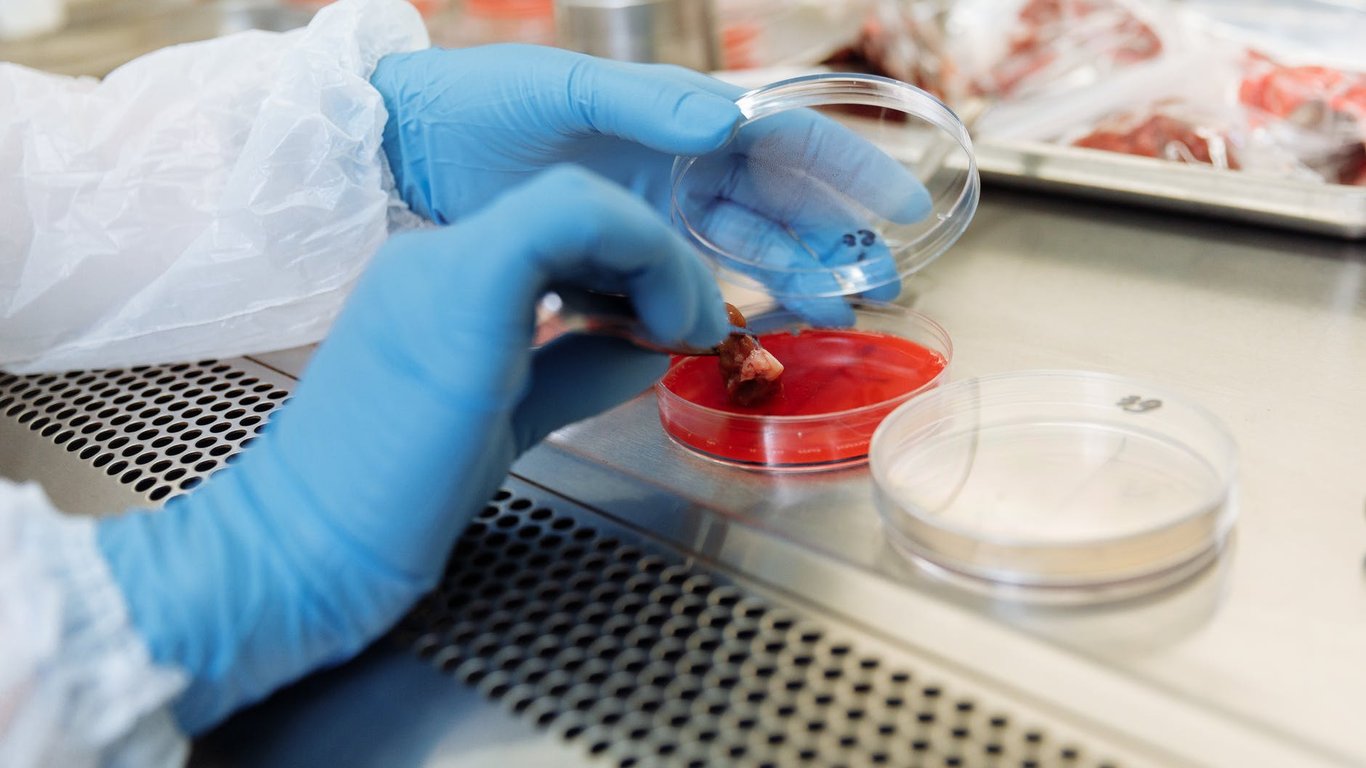

В Одесской области обнаружили вспышку гриппа и кишечных инфекций: что известно
В Одесской области зафиксировали несколько фактов ухудшения эпидемиологической ситуации в нескольких регионах вспышка гриппа и кишечная инфекция.
Об этом сообщает ГУ"Одесский областной центр контроля и профилактики болезней МОЗ Украины"
Читайте также: "Температура под 40 и щемящую боль в животе": почему в детсадах Одесской области регулярно травятся дети
Что обнаружили в ходе проверки
В течение прошлой недели уровень заболеваемости ОРВИ снизился, сейчас в лечебные учреждения госпитализировали 924 человека, что выше предыдущей недели на 1,5%. Впрочем, в 7-ми территориях области эпидемический порог заболеваемости ОРВИ превышает норму, на 2-х из них более чем на 25% (Килийский и Николаевский районы).
COVID-19 тем временем в области идет на спад по сравнению с предыдущей неделей. Общий уровень заболеваемости снизился в 2 раза (3554 случаев против 6970) за счет взрослого населения, где также снижение в 2 раза (3324 против 6658), среди детей - на 26,3% (230 против 312).
Кишечные инфекции
Впрочем, уровень заболеваемости острыми кишечными инфекциями в Одесской области срез в почти 2 раза, в том числе среди детей в возрасте до 17 лет - в 1,9 раза, а среди взрослых - на 7 случаев.
На минувшей неделе зарегистрировано 2 вспышки острого гастроэнтероколита ротавирусной этиологии: в КУ "Социальный центр матери и ребенка", что в городе Одесса. Там заболело 6 детей, которых госпитализировали в КНП "Городская детская больница №2". Их состояние оценивают как средней тяжести. У них предварительно диагностировали острый гастроэнтероколит, впрочем лабораторные исследования подтвердили ротавирус, из них у 3-х комбинированные кишечные инфекции. Также ротавирус обнаружили у 8-ми контактных лиц (4 ребенка, 3 матери и уборщица), из них у одной матери микст-инфекция (ротавирус+кампилобактерия).
Еще один палах кишечной инфекции в течение прошлой недели зафиксировали в дошкольном учебном заведении ясли-садик "Родничок" с. Виноградовка Болградского района. Всего заболело 11 человек, из них 10 детей и 1 взрослый. Все больные госпитализированы в КНП "Болградская центральная районная больница", из них у 2-х течение легкое, у 9-ти – средней тяжести.
Причина вспышки кишечной инфекции
Как сообщают в ведомстве, причиной является нарушение санитарно-гигиенического и противоэпидемического режима в жилых комнатах и помещениях общего пользования.
Больше новостей
-
В Одесской области во время проверок на носительство стафилококка патогенную бактерию обнаружили у 76 работников учреждений дошкольного образования и у 104 работников учреждений общего среднего образования.